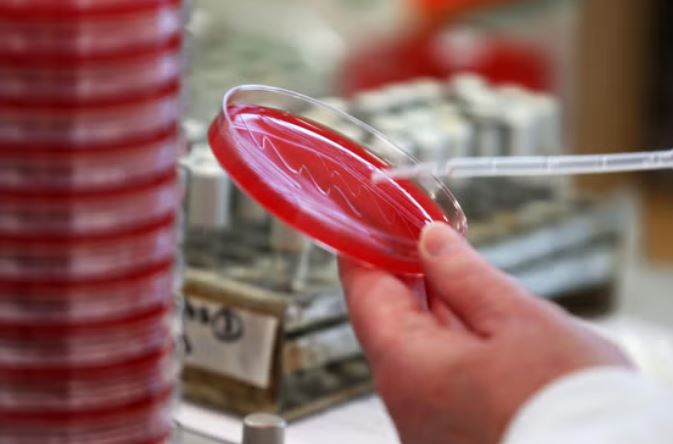

العدوى المقاومة للمضادات تقتل الملايين حول العالم هذا العام

حذر علماء من أن أكثر من 39 مليون شخص معرضون للوفاة بسبب العدوى المقاومة للمضادات الحيوية حتى عام 2050.
وبحسب صحيفة "اندبيندنت" البريطانية، أشارت البيانات إلى أن أكثر من مليون شخص ماتوا بسبب العدوى المقاومة للأدوية على مستوى العالم كل عام بين عامي 1990 و2021.
ووجد التحليل العالمي الجديد الذي أجراه مشروع البحث العالمي حول مقاومة مضادات الميكروبات (جرام) أن الوفيات الناجمة عن مقاومة مضادات الميكروبات (AMR) بين الأطفال دون سن الخامسة انخفضت بنسبة 50% خلال هذه الفترة الزمنية.
ومع ذلك، فقد زاد خطر الوفاة بنسبة تزيد عن 80% بين الأشخاص الذين تبلغ أعمارهم 70 عامًا أو أكثر.
وتسلط النتائج، التي نشرت في مجلة لانسيت، الضوء على الحاجة إلى اتخاذ تدابير تجمع بين الوقاية من العدوى والتطعيم والحد من الاستخدام غير المناسب للمضادات الحيوية والبحث في المضادات الحيوية الجديدة للتخفيف من عدد الوفيات الناجمة عن مقاومة مضادات الميكروبات المتوقعة بحلول عام 2050.
وأشارت الدراسة أيضًا إلى أن 1.91 مليون شخص معرضون كنتيجة مباشرة لمقاومة مضادات الميكروبات في عام 2050، وهو ما يمثل زيادة بنحو 70% سنويًا مقارنة بعام 2022.
وعلى مدى الفترة نفسها، سيرتفع عدد الوفيات التي تلعب فيها البكتيريا المقاومة لمضادات الميكروبات دورًا بنسبة 75% تقريبا، من 4.71 مليون إلى 8.22 مليون سنويا.
تحدث مقاومة مضادات الميكروبات عندما تتطور البكتيريا والأمراض بحيث لم تعد تستجيب للأدوية المصممة لعلاج العدوى، وقال الدكتور محسن نجفي، مؤلف الدراسة ورئيس فريق أبحاث مقاومة مضادات الميكروبات في معهد مقاييس الصحة (IHME)، بجامعة واشنطن في الولايات المتحدة: "إن الأدوية المضادة للميكروبات هي أحد أحجار الزاوية في الرعاية الصحية الحديثة، وزيادة المقاومة لها هو سبب رئيسي للقلق.
"وأضاف محسن نجفي: "تسلط هذه النتائج الضوء على أن مقاومة مضادات الميكروبات كانت تشكل تهديدًا صحيًا عالميًا كبيرًا لعقود من الزمن وأن هذا التهديد آخذ في النمو."
وقال الدكتور كيفن إيكوتا، من جامعة كاليفورنيا في لوس أنجلوس وأستاذ مشارك في معهد القياسات الصحية والتقييم، إن الانخفاض في الوفيات الناجمة عن الإنتان ومقاومة مضادات الميكروبات بين الأطفال الصغار على مدى العقود الثلاثة الماضية يعد إنجازًا لا يصدق، ولكن التهديد الذي يواجه كبار السن لن يزداد إلا مع تقدم السكان في السن.
وأضاف: "الآن هو الوقت المناسب لإتخاذ التدابير اللازمة لحماية الناس في جميع أنحاء العالم من التهديد الذي تشكله مقاومة مضادات الميكروبات".


 تابعوا آخر أخبار بوابة الوفد الإلكترونية عبر نبض
تابعوا آخر أخبار بوابة الوفد الإلكترونية عبر نبض